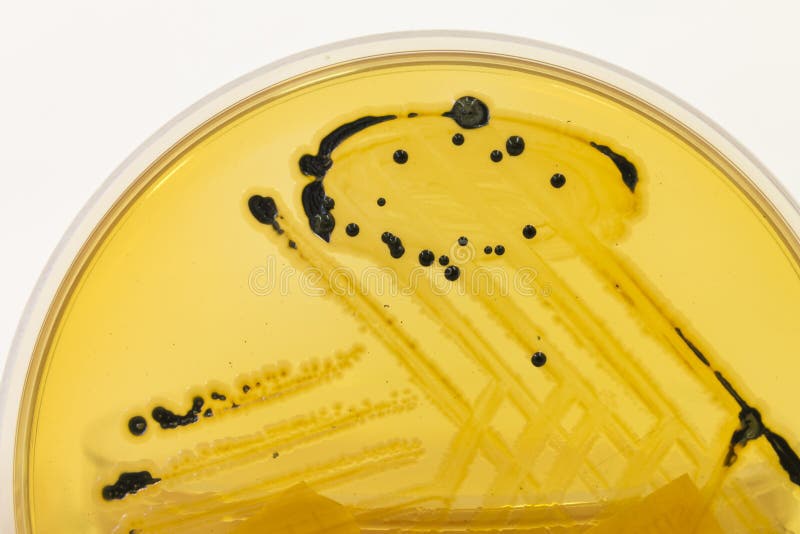

Long before the arrival of the 'Germ theory of disease',the Vedas housed a portion which describes pathogens and the specific sound formulae one needs to produce to destroy them.
The Vedas,originally received as cosmic sounds which were heard and experienced by various sages,were organised into divisions as the volume was too enormous.
In general,people know it as the 4 Vedas - Rg,Yajur,Saama and Atharva
The Yajur Veda is classified into Shukla and Krshna Yajur Veda.There is a branch of Krshna Yajuveda known as the Taittriya Shaakha.In this Shaakha ( branch ) , the Mantra Bhaaga ( original text in sound form ) and Braahmana Bhaaga ( that which contains commentaries,meanings and applications of the original texts ) are inter-mixed and there is no clear boundary of these parts in any portion of this Veda.Hence,the name Krishna Yajur Veda - meaning unclear ( not 'BLACK YAJUR VEDA as postulated by many )

The Taittriya Shaakha has many divisions - Samhita,Braahmana,Aaranyaka,Upanishad and Mantra Prashna-s
Aaranyaka refers to forest treaties - the lessons learnt traditionally in the forest regions.
The Aaranyaka of the Taittriya Shaakha of Krshna Yajur Veda has a portion that speaks on germs and the mantra ( sound formulae ) that can destroy them.This is found in the 4th Chapter, Anuvakas 36 & 37
Text in Devanaagari with svara markings :
Meanings :
(1) O Germ ! I kill you with the Mantra ( following verses ) revealed to the Rishis Atri,Kanva and Jamadagni
Sage Atri's wife is Anasuya - one of the seven pativratas in the Vedic tradition.Lord Dattatreya is their son.

Sage Kanva is the foster father of Shakuntala.Sage Jamadagni is the father of Parashurama.

(2) With the powers of Vishvaavasu ( a Gandharva ) and Brahman,I kill the King of germs !

(3) Also, may sthapati(divinity resident in the particular sthaana or place) kill ALL of these germs!
(4) And their mother, and their father! And their leaders and their commoners!
![]() |
Division of Bacteria to form a colony |
(5) And their dark ones and their white ones! And the most determined of them be killed too! Their principal chiefs and their followers too.
(6) Eat up these unspeakable monsters offered in the shruta yajna-havis! This is verily the Truth!
(7) By recitation of the sound formulae 'khaNphaNmrasi', I offer all of them into the open jaws of Yama,The lord of Death ! ( May He chew them up )
(8 ) OM Shanti : shanti : shanti :

Feedback I received :

ALSO READ :
(1) Origin of Vedas - The Genesis
.
Where are tantras in your classification of tantras?
ReplyDeleteI don't get your question
DeletePranam Maharaj, Dhanyavadh , Hari Om Tat Sat - Om Shanti Shanti Shanti
ReplyDeleteYes i am totally agreed with this article and i just want say that this article is very nice and very informative article.I will make sure to be reading your blog more. You made a good point but I can't help but wonder, what about the other side? !!!!!!Thanks sanitizer sprayer machine
ReplyDeleteHow do we get connected over what’s up regards dr rajshri
ReplyDeleteWhatsapp to +60163059916
Delete